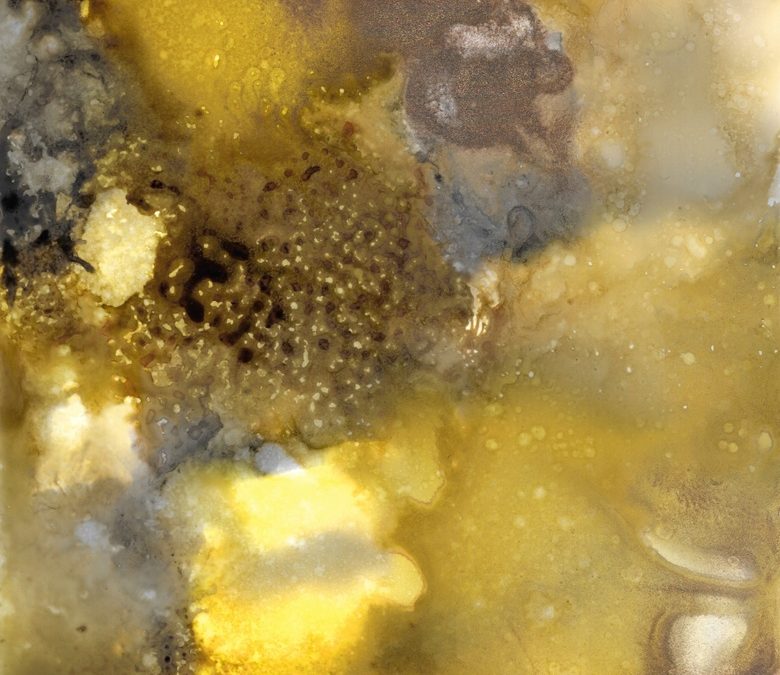
Scrambled Eggs

by LyndaFerris | Jul 1, 2025
Spring Orb 4.5″ x 6″ • Alcohol Ink on Synthetic Paper •...

by LyndaFerris | Jul 1, 2025
Scrambled Eggs 4.5″ x 6″ • Alcohol Ink on Synthetic Paper •...

by LyndaFerris | Jul 1, 2025
Tall 4.5″ x 6″ • Alcohol Ink on Synthetic Paper •...

by LyndaFerris | Jul 1, 2025
Unnamed #24.5″ x 6″ • Alcohol Ink on Synthetic Paper •...